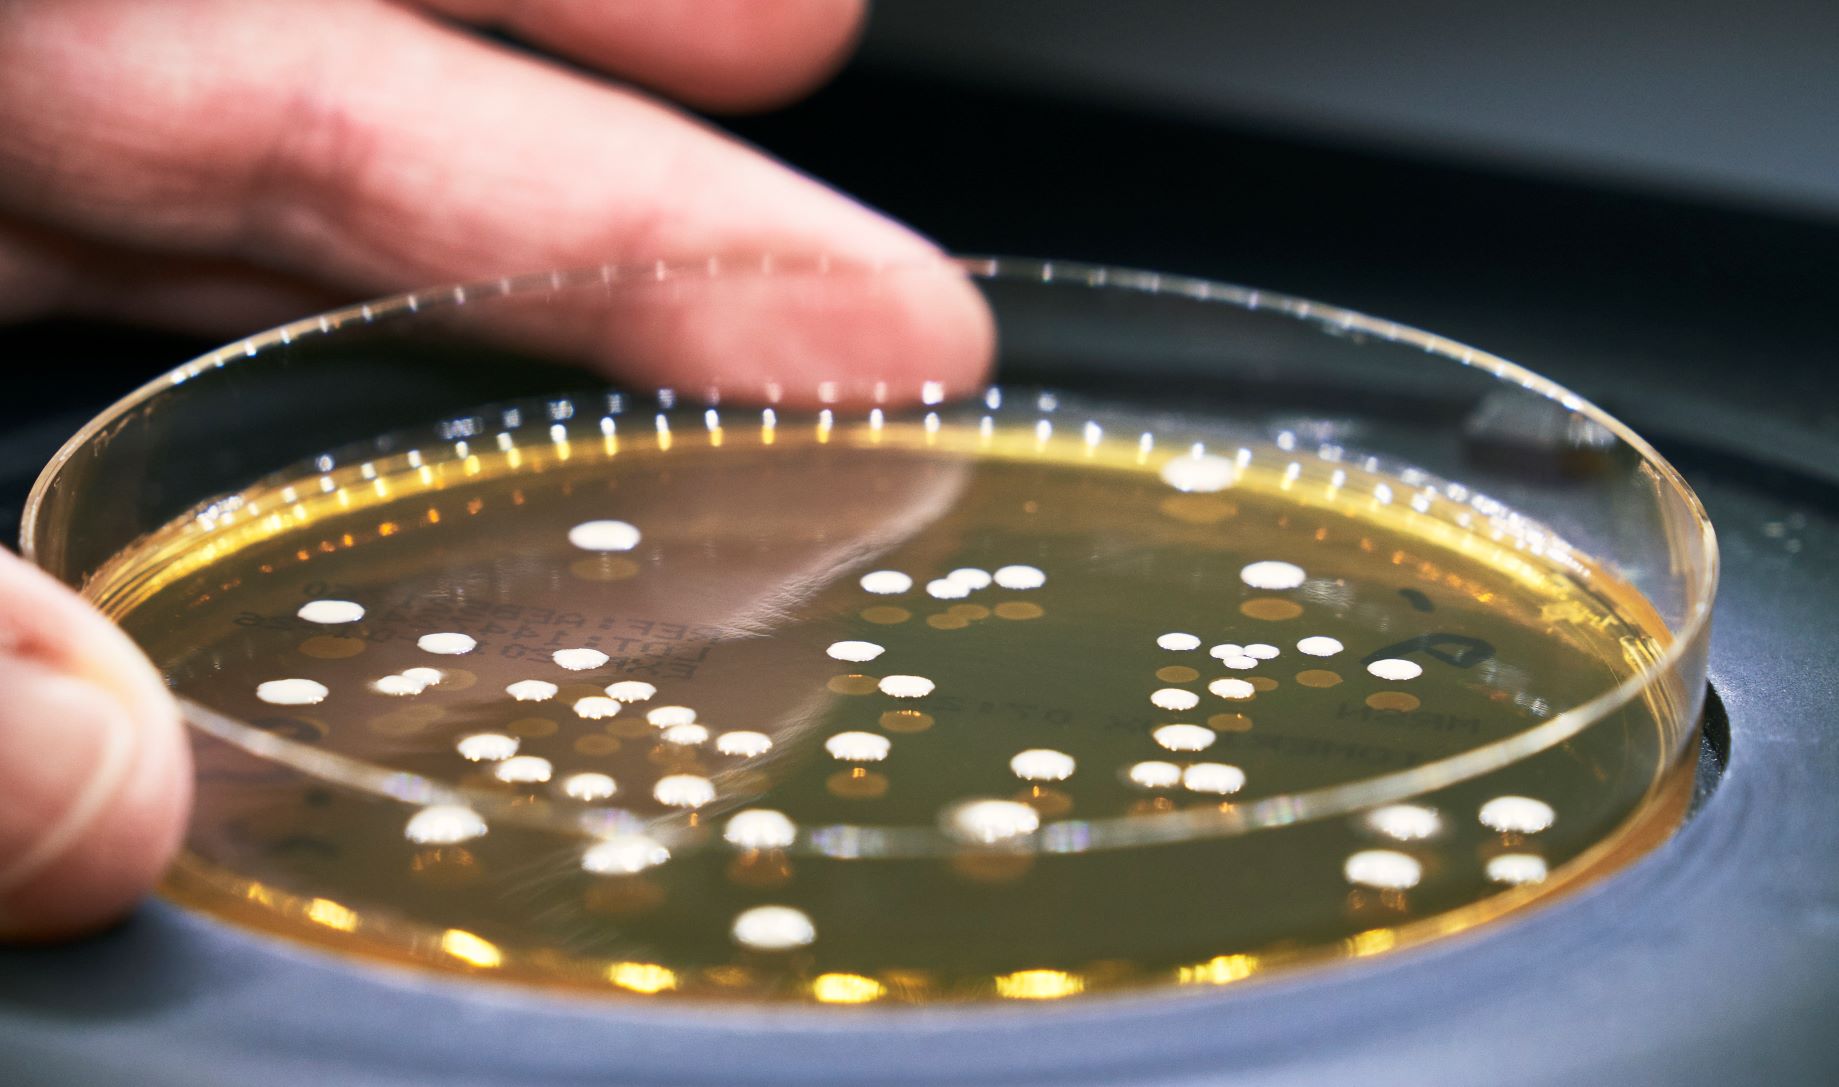

Why probiotics?
More than 70% of our immune system is controlled from our stomach and gut - and half of the cells related to the immune system are found in our gut. This means that probiotics can have a positive impact on our immune system, as they can change the composition of bacteria in our gut flora. Our gut flora also plays a key role in enabling humans to absorb essential nutrients, produce vitamins and maintain good gastrointestinal health. They can also contribute to a strengthened natural protective barrier - against less favorable bacteria, viruses, and other components that we are exposed to daily.
Our gut contains a natural array of billions of bacteria, and each person has a unique composition of bacteria in the gut that maintains our well-being. However, if this microbiological flora in the stomach and gut is disturbed, the natural bacteria may need some help.
The composition of our gut flora can be altered by things like a change in diet, illness, the use of different medications such as antibiotics, and by increased stress.
Where are live and good bacteria found?
Live and beneficial bacteria are present in some foods - either naturally, as a result of cooking processes or by adding probiotic strains to the food. Many foods contain naturally living bacteria, such as fresh fruits and vegetables. There are also foods that contain good and beneficial bacteria by undergoing a fermentation process. This process involves a lactic acid fermentation that lowers the pH of the food, which in turn leads to the growth of good bacteria while the spoilage bacteria do not thrive. Thus, a fermentation process results in the food containing many strains of live and beneficial bacteria.
Examples of foods that have undergone fermentation are yoghurt, kefir, fermented carrots, miso, and kimchi. However, this does not apply if the products are pasteurized - that is, they have been heat-treated. If the products are cooked at a heat above about 45 degrees, the bacteria die.
Live bacteria are also available as food supplements, including in capsule form, and help people to ingest a larger amount of bacteria at the same time. Probi’s probiotic supplements also contain one or more well-defined bacterial strains with proven health benefits, compared to foods with undefined bacterial strains.